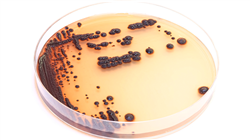
##IMAGE##

Университетская квалификация
Крупнейший в мире фармацевтический факультет”
Презентация
Благодаря данному Курсу профессиональной подготовки на 100% онлайн вы углубите свои знания о молекулярных методах, новых антимикробных молекулах и применении искусственного интеллекта в клинической микробиологии”
В связи с тревожным ростом числа инфекций, не поддающихся лечению из-за мультирезистентности, подчеркивается важность эпидемиологического надзора, строгого соблюдения мер инфекционного контроля и непрерывного обучения медицинских работников. Фармацевты играют важную роль в обеспечении надлежащего использования антибиотиков и поощрении ответственного подхода к их назначению.
Данный Курс профессиональной подготовки был создан для того, чтобы предоставить фармацевтам глубокие и актуальные знания о ключевых инновациях в области микробиологии и антимикробной терапии. Будет подробно рассмотрено использование передовых молекулярных технологий, таких как редактирование генов CRISPR-Cas9, с указанием их специфического механизма действия и потенциального применения в борьбе с мультирезистентными бактериями.
Студенты изучат всестороннюю оценку новых антимикробных молекул, а также проанализируют их механизмы действия, антимикробный спектр, терапевтическое применение и побочные эффекты. Специалисты будут различать различные группы антибиотиков и критически оценивать характеристики, которые делают каждую новую молекулу перспективным вариантом борьбы с резистентными инфекциями.
Будет рассказано о применении искусственного интеллекта и показано, как алгоритмы и модели ИИ могут революционизировать методы изучения и борьбы с бактериальной резистентностью. В программе будут рассмотрены его исторические основы и эволюция в этом контексте, а также его практическое применение в клинических лабораториях и микробиологических исследованиях. Кроме того, будут рассмотрены стратегии взаимодействия между ИИ и здравоохранением с упором на управление вспышками заболеваний, эпидемиологический надзор и персонализацию лечения.
Данный курс предоставит студентам методику на 100% онлайн, что позволит им строить свой учебный график в соответствии с личными и профессиональными обязательствами. Кроме того, в обучение будет внедрена инновационная методология Relearning, которая способствует глубокому пониманию ключевых понятий путем повторения. Студенты смогут учиться о в своем собственном темпе и полностью изучить новейшие научные данные.
Вы получите глубокое понимание самых передовых молекулярных методов и изучите новые противомикробные молекулы, различая их механизмы действия и терапевтическое применение”
Данный Курс профессиональной подготовки в области передовых стратегий борьбы с мультирезистентными бактериями содержит наиболее полную и современную научную программу на рынке. Основными особенностями обучения являются:
- Разбор практических кейсов, представленных специалистами в области микробиологии, медицины и паразитологии
- Наглядное, схематичное и исключительно практическое содержание курса предоставляет научную и практическую информацию по тем дисциплинам, которые необходимы для осуществления профессиональной деятельности
- Практические упражнения для самооценки, контроля и улучшения успеваемости
- Особое внимание уделяется инновационным методологиям
- Теоретические занятия, вопросы эксперту, дискуссионные форумы по спорным темам и самостоятельная работа
- Учебные материалы курса доступны с любого стационарного или мобильного устройства с выходом в интернет
Вы будете анализировать алгоритмы и модели искусственного интеллекта для предсказания структуры белков, выявления механизмов резистентности и анализа больших объемов геномных данных. Записывайтесь сейчас!"
Преподавательский состав программы включает профессионалов отрасли, которые привносят в обучение опыт своей работы, а также признанных специалистов из ведущих сообществ и престижных университетов.
Мультимедийное содержание программы, разработанное с использованием новейших образовательных технологий, позволит специалисту проходить обучение с учетом контекста и ситуации, т.е. в симулированной среде, обеспечивающей иммерсивный учебный процесс, запрограммированный на обучение в реальных ситуациях.
Структура данной программы основана на проблемно-ориентированном обучении, с помощью которого специалист должен попытаться разрешать различные ситуации из профессиональной практики, возникающие в течение учебного курса. В этом специалистам поможет инновационная интерактивная видеосистема, созданная признанными экспертами.
Вы познакомитесь с новыми молекулярными технологиями, в частности с революционным методом редактирования генов CRISPR-Cas9, с помощью лучших учебных материалов, представленных на академическом рынке, на переднем крае технологий и образования"
Выбирайте TECH! Вы будете различать различные группы антибиотиков, такие как пенициллины, цефалоспорины, карбапенемы и другие, что необходимо для обоснованного и стратегического назначения препаратов в фармацевтической практике"
Цели
Основная цель программы – предоставить фармацевтам специальные знания и передовые инструменты для эффективного решения растущей проблемы мультирезистентных бактерий. Таким образом, новые стратегии, такие как редактирование генов CRISPR-Cas9, и исчерпывающий анализ новых антимикробных молекул будут подробно изучены, чтобы оптимизировать терапию и минимизировать побочные эффекты. Искусственный интеллект будет интегрирован в клиническую микробиологию, а специалисты получат навыки использования передовых алгоритмов и моделей для раннего выявления резистентности и персонализации лечения.
Данный Курс профессиональной подготовки был разработан для того, чтобы вооружить фармацевтов специальными знаниями и передовыми навыками, необходимыми для решения растущей проблемы мультирезистентных бактерий”
Общие цели
- Приобрести опыт в создании новых противомикробных молекул, включая противомикробные пептиды и бактериоцины, ферменты бактериофагов и наночастицы
- Развивать экспертные знания о методах открытия новых антимикробных молекул
- Получить специализированные знания по искусственному интеллекту (ИИ) в микробиологии, включая текущие ожидания, новые области и их трансверсальность
- Понять, какую роль будет играть искусственный интеллект в клинической микробиологии, в том числе особенности и технические проблемы, связанные с его внедрением и развертыванием в лабораториях
Конкретные цели
Модуль 1. Новые стратегии борьбы с мультирезистентными бактериями
- Глубоко изучить механизм действия различных молекулярных методов для использования против мультирезист
ентных бактерий, включая геномное редактирование CRISPR-Cas9, его молекулярный механизм действия и возможности применения
Модуль 2. Новые противомикробные молекулы
- Проанализировать механизмы действия, антимикробный спектр, терапевтическое применение и побочные эффекты новых противомикробных молекул
- Различать новые противомикробные молекулы среди семейств антибиотиков: пенициллины, цефалоспорины, карбапенемы, гликопептиды, макролиды, тетрациклины, аминогликозиды, хинолоны и другие
Модуль 3. Искусственный интеллект в клинической микробиологии и инфекционных заболеваниях
- Проанализировать основы ИИ в микробиологии, включая его историю и развитие, технологии, которые могут быть использованы в микробиологии, и цели исследования
- Включать алгоритмы и модели искусственного интеллекта для предсказания структуры белков, выявления и понимания механизмов резистентности, а также геномного анализа больших данных
- Применять ИИ в методах машинного обучения для идентификации бактерий и его практическое применение в клинических и исследовательских лабораториях микробиологии
- Изучить стратегии синергии с ИИ микробиологии и здравоохранения, включая управление вспышками, эпидемиологический надзор и персонализированные методы лечения
Вы познакомитесь со стратегическим использованием искусственного интеллекта в микробиологии, способствующим прогнозированию резистентности, оптимизации лечения и внедрению практик общественного здравоохранения”
Курса профессиональной подготовки в области передовых стратегий борьбы с мультирезистентными бактериями
Курс профессиональной подготовки в области новых стратегий борьбы с мультирезистентными бактериями, созданный TECH Технологическим университетом , - это специализированная программа, предназначенная для специалистов здравоохранения, которые хотят приобрести передовые навыки и знания в области эффективного лечения инфекций, вызванных бактериями, резистентными к множеству антибиотиков. Данный курс, предлагаемый на 100% онлайн, обеспечивает глубокое понимание новейших стратегий и инновационных подходов к решению этой растущей проблемы. В рамках данного курса вы изучите механизмы бактериальной резистентности, эпидемиологию мультирезистентных бактерий и новые стратегии рационального использования противомикробных препаратов. Кроме того, будут рассмотрены такие ключевые темы, как выявление резистентных штаммов, разработка персонализированных методов лечения и внедрение мер инфекционного контроля и профилактики в различных медицинских учреждениях. Отличительной особенностью этого курса является его направленность на передовые стратегии и применение инновационных технологий в области клинической микробиологии. Вы узнаете об использовании молекулярных инструментов, методов экспресс-диагностики, комбинированных методов лечения и роли микробиоты в лечении мультирезистентных бактериальных инфекций.
Освойте новые стратегии борьбы с мультирезистентными бактериями
Онлайн-режим курса обеспечивает гибкость и доступность, позволяя вам получать доступ к материалам из любой точки мира и в удобное время. Благодаря передовой образовательной платформе вы сможете воспользоваться интерактивными ресурсами и современными учебными материалами по клинической микробиологии и резистентности к противомикробным препаратам. Курс ведет команда профессионалов с большим опытом работы в области мультирезистентных бактерий и разработки передовых стратегий их клинического лечения. Их практический опыт и современные знания гарантируют высокое качество обучения, соответствующее современным требованиям в области здравоохранения. Поступление Курс профессиональной подготовки - это стратегическое решение для специалистов здравоохранения, которые хотят быть на передовой в лечении сложных инфекций и внести свой вклад в развитие борьбы с резистентностью к противомикробным препаратам. Эта инновационная программа предоставляет инструменты и знания, необходимые для эффективного решения проблемы мультирезистентных бактерий в клинических условиях.